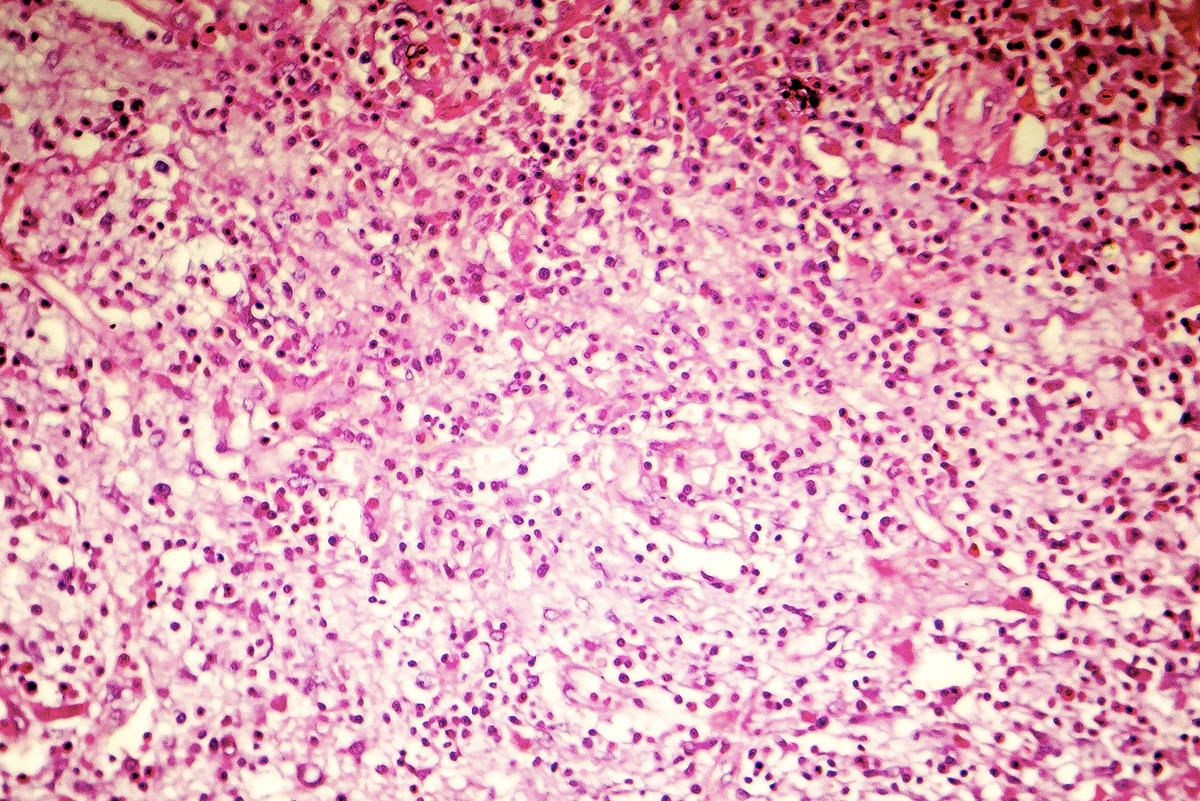

Eosin Y oder Eosin G (von altgriechisch ἠώς ēōs „Morgenröte“), generischer Name C.I. Acid Red 87 oder C.I. 45380, kurz auch Eosin genannt, ist ein roter, erstmals 1871 von Heinrich Caro hergestellter Säurefarbstoff aus der Gruppe der Xanthenfarbstoffe wie auch der Triphenylmethanfarbstoffe und kann zum Färben von Textilien und Papier verwendet werden. Die wässrige Lösung des Farbstoffs fluoresziert grünlich.
Neben dem üblicherweise eingesetzten Eosin Y (für englisch yellowish „gelblich“), wird auch das Eosin B (für englisch bluish „bläulich“) verwendet, das im Gegensatz zum Gelbstich von Eosin Y einen Blaustich zeigt. Beim Eosin B sind zwei der Bromatome durch Nitrogruppen ersetzt. Die Eosine leiten sich von Fluorescein ab.
Eigenschaften
Für das Dianion von Eosin y lassen sich verschiedene mesomere Grenzstrukturen formulieren, die den aromatische Charakter des Chromophors verdeutlichen.
Verwendung
Medizin
Hauptanwendungsgebiete sind die Medizin und Biologie, wo Eosin Y zum Färben von Zellen, u. a. im Blut (siehe auch eosinophile Granulozyten und Hämatoxylin-Eosin-Färbung) dient. Dabei werden Zellbestandteile wie z. B. das Zytoplasma rötlich angefärbt. Neben Eosin Y kann für manche Anwendungen auch Eosin B eingesetzt werden.
Eosin Y und ähnliche Farbstoffe wurden – bevor sich Cortison durchsetzte – z. B. zur Behandlung von offener Neurodermitis eingesetzt: Pilze und Bakterien werden abgetötet und die Haut bei der Heilung unterstützt.
Eosin Y kommt eine desinfizierende Bedeutung zu und wird von Hautärzten – als Ersatz für Mercurochrom – in der Form einer z. B. zweiprozentigen wässrigen Lösung zur Wunddesinfektion bzw. -heilung eingesetzt. Allerdings wirkt es nur schwach antibakteriell und die Wirksamkeit ist zudem vom pH-Wert abhängig.
pH-Indikator
Eosin wird außerdem als pH-Indikator eingesetzt. Eosin Y schlägt bei ca. pH 2 von gelb (< 2) auf grün-fluoreszierend (> 2) um. Eosin B schlägt bei ca. pH 1,7–1,8 von farblos (<≈ 1,7) auf rosa-fluoreszierend (>≈ 1,7) um, ist jedoch für diesen Zweck nicht sehr weit verbreitet.
Quantitative Halogenidbestimmung nach Fajans
Eosin Y eignet sich ebenso als einfacher sehr präziser Indikator bei Fällungstitrationen. Ein Analyt, der eine unbekannte Konzentration an Iodidionen enthält, wird mit einer AgNO3-Maßlösung bis zur Flockenbildung (durch schwerlöslichem AgI) bestimmt. Nach Überschreiten des Äquivalentpunktes sind die AgI-Kolloide durch überschüssige Ag -Ionen an der Oberfläche positiv aufgeladen und vermögen Eosinanionen zu adsorbieren, was durch Wechselwirkung mit dem delokalisierten π-Elektronensystem des Farbstoffs zu einer Farbänderung führt. Man erkennt einen scharfen Farbumschlag von gelb nach rosa.
Farbstoff
Bis in die 1980er-Jahre verwendete man Eosin Y als Farbstoff in Lippenstiften. Wegen der toxischen Wirkung wurde es seither durch Pigmente ersetzt.
Hydrologie
In der Hydrologie wird Eosin Y für Färbeversuche eingesetzt. Da es sehr lichtempfindlich ist, wird es hauptsächlich für Grundwasserfragen verwendet.
Weblinks
- Chemieunterricht.de: Eosin als rote Tinte
Einzelnachweise